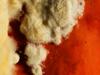

Dynia olbrzymia
Cucurbita maxima
Dynia olbrzymia (Cucurbita maxima Duchesne) – gatunek rośliny z rodziny dyniowatych. Pochodzi z Ameryki Środkowej i Południowej. Były uprawiane już 3000 lat przed naszą erą. Główne rejony uprawy to obecne tereny Meksyku, Gwatemali i południowe rejony USA. Na tym obszarze występują dzikie gatunki C. lundelliana Bailey oraz C. martinezii Bailey. Niektóre źródła podają, że dynie były znane i uprawiane już 5000–7000 lat p.n.e. Gatunki Cucurbita trafiły do Europy za pośrednictwem hiszpańskich żeglarzy, potem rozprzestrzeniły się na inne kontynenty. W Polsce uprawiana jako roślina jednoroczna, czasem (rzadko) dziczejąca (efemerofit).
Uprawiana jako warzywo. Owoce są jadalne. Miąższ owoców jest jadalny po ugotowaniu (np. jako zupa z dyni), można go też kandyzować i wytwarzać marmoladę. Cenione są również pestki dyni: zarówno do bezpośredniego spożycia, jak również w postaci tłoczonego z nich oleju. Na terenie obecnego Peru uprawiana była już od ok. 2000 lat i była jedną z głównych roślin uprawianych przez Inków dla celów spożywczych. Według badań Szweykowskich uprawiana była tam już w neolicie. Do Europy została sprowadzona przez Hiszpanów w ok. 50 lat po wyprawie Krzysztofa Kolumba. W Polsce znana była również już w XVI w., uprawiano ją wtedy u nas jako roślinę leczniczą Nadaje się również na paszę dla zwierząt. Dynia olbrzymia jest gatunkiem dobrze rosnącym w polskich warunkach klimatycznych i dającym wysokie plony. Odpowiedni skład soli, znaczna zawartość karotenoidów i niska zdolność do wiązania azotanów sprawiają, że stanowi ona cenny surowiec dla przemysłu. Mała popularność tej rośliny w Polsce spowodowana jest brakiem tradycji uprawy dyni na dużych powierzchniach. Dynia wykorzystywana jest również w gorzelnictwie, ze względu na dużą zawartość suchej masy, konkuruje z ziemniakiem, w piekarnictwie, przetwórstwie owocowo – warzywnym do produkcji mrożonek, dżemów itp., oraz jako pasza dla zwierząt. Ze względu na wysoką zawartość beta-karotenu (prowitaminy A) i niską zdolność wiązania azotanów z gleby jest wykorzystywana jako surowiec do produkcji soków owocowo-warzywnych. Owoc dyni znajduje zastosowanie również jako składnik odżywek dla niemowląt. Istnieją odmiany o bardzo kolorowych i charakterystycznego kształtu owocach, uprawiane jako rośliny ozdobne (tzw. dynia ozdobna). Należy do nich np. Cucurbita maxima var. turbaniformis, której owoce mają kształt turbanu i są dwukolorowe. Z nasion wyjątkowo dużych owoców nazywanych 'Atlantic Giant' uprawiane są rośliny głównie z zamiarem osiągnięcia nowego rekordu.
Źródło informacji: Wikipedia : wolna encyklopedia [dostęp: 2024-03-08 21:17:10]. Dostępny w internecie: https://pl.wikipedia.org/w/index.php?oldid=72616938. Główni autorzy artykułu w Wikipedii: zobacz listę.
- cechy łodygi
- szacowana wysokość łodygi
- wyższa od człowieka (> 200 cm)
- wygląd łodygi
- łodyga pełzająca
- cechy kwiatów
- barwa kwiatów
- płatki żółte
- płatki kremowe
- liczba płatków
- płatki trzy i mniej
- płatków pięć
- symetria kwiatu
- grzbiecista
- cechy owoców
- rodzaj owoców
- mięsiste
- jagoda
- kolor owoców
- żółte
- zielone
- pomarańczowe
- ogólne
- roślina lecznicza
- roślina jadalna
- roślina ozdobna
- roślina użytkowa
- roślina pyłkodajna
- roślina jednoroczna
- status gatunku we florze Polski
- efemerofit
- warzywo